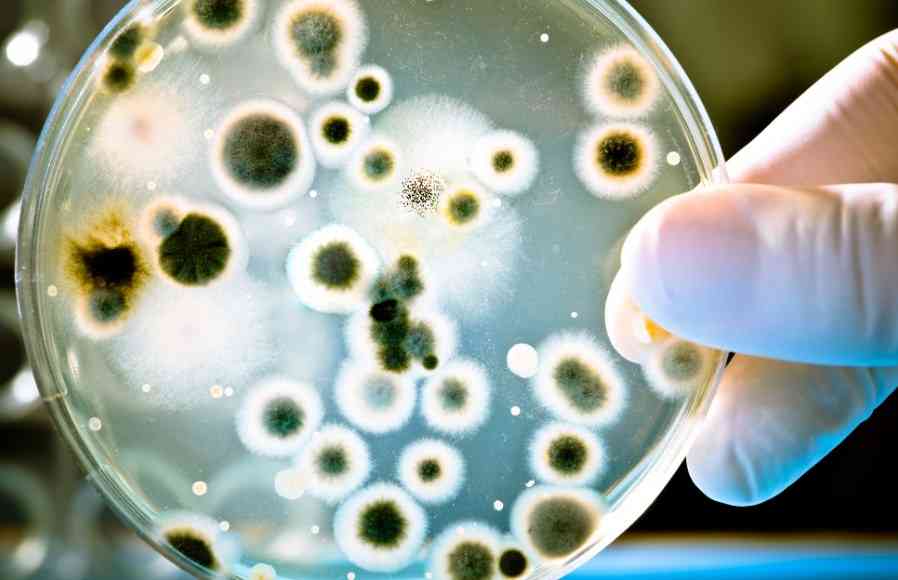
плесневый грибок

Устрицы – продукт с эксклюзивным вкусом, считающиеся мировым деликатесом, обитающие в соленой воде и употребляемые ещё древнем мире. Но иногда встреча с этими моллюсками может не принести удовольствие, а закончится безрадостными симптомами отравления устрицами.
Возможно ли отравиться устрицами
Устрицы – хитрый продукт. Может стать плохо от напитка сопровождающего устрицы. Стоит помнить о том, что эти моллюски содержат очень много легкоусвояемого белка. Но случаи пищевого устричного отравления встречаются не редко. Фиксируются случаи летальных исходов.

Женщинам, переносящим беременность, живые устрицы употреблять запрещено.
Виды отравления
Основными возбудителями отравления являются вирусы и бактерии.
- Норовирус, чаще всего отравление устрицами случается из-за этого возбудителя;
- Кампилобактериоз, бактерия животного происхождения, больше всего распространена среди теплокровных животных, чья продукция употребляется в пищу, но также замечена и у моллюсков;
- Вибрио вулнификус;
- Передозировка йодом или белком, зависит от того на сколько много было употреблено;
- Галофилёз.

Передозировка связана с составом устрицы.
Чуть больше четверти людей на Земле имеют аллергию на морской белок и переедание может привести к проявлению аллергии.
Какие симптомы
- Норовирус:
Инкубационный период составляет от 1 до 3 суток. Основным индикатором вируса является выделение им токсина, который влияет на потерю вкуса. Спустя сутки наступает сильнейшее обезвоживание. Сопутствующие проявления: повышенная температура и остальные симптомы пищевого отравления.
- Кампилобактериоз:
Инкубационный период: до 5 суток, но процесс может затянуться и до 10 суток. Проявляется болью в животе, диареей, высокой температурой, мигренью, метеоризмом. Осложнения могут начаться лишь у маленьких детей, старых людей, или если человек переносит другой серьезный недуг (синдром иммунодефицита или подобные ему).

- Вибрио вульнификус:
Чаще всего, данный вид вируса, человек получает при неправильном приготовлении устриц. Инкубационный период до 1 суток. Можно зафиксировать слабость, тошноту (реже), стул, повышенную температуру.

- Передозировка:
Температура тела достигает 39 градусов, повышенное давление, пропавший аппетит, дрожь в конечностях, бессонница, чувство нехватки воздуха, жар.
- Галофилёз:
Инкубационный период – четверть дня. Возникает резкая боль в районе живота, появляются симптомы интоксикации. Особо опасен из-за возможности сильно обезводить организм.
Одним из последствий купания в загрязнённой соленой воде может стать Галофилёз.
Через сколько появляются
Норовирус: симптомы проявляются после инкубационного периода. Могут происходить не однократные симптомы интоксикации. Этот период длиться до 3 суток.
Кампилобактер: все проявления бактерии заканчиваются после 5 суток.
Вибрио вульнификус: резкое кишечное расстройство дающее о себе знать по окончании инкубационного периода. Проявления хаотично уходят в течении 3 суток.
Из-за быстрого размножения вибриона, появления симптомов Галофилёза могут начать проявляться уже спустя 6 часов.
Причины непригодности устриц
- Преждевременная смерть устриц;
- Наличие косметических дефектов на скелете моллюска;
- Цвет и мягкость-твердость моллюска;
- Неправильное открытие устричного скелета, в следствии чего частички раковины могут попасть во внутрь;
- Экология места, в котором вылавливалась устрица.
Существует утверждение, что идеальное время для устриц наступает, когда в названии месяца есть буква «р», то есть в летнее время стоит воздержаться от добавления в рацион устриц. Но в условиях современной действительности, когда появились холодильные машины, это правило теряет свою актуальность.

Одним из важных признаков живой устрицы является крепко соединенные створки.
Лечение
Лечение от Норовируса должно включать напитки и растворы для нормализации водно-солевого баланса, в качестве лечебного средства подойдет Регидрон. Для взрослого человека на один килограмм массы должно приходиться по 60 мл воды в первые часы заболевания. Также рекомендуются препараты содержащие соли натрия и калия. Без лечения инфекция уходит сама уже к 3 дню, так как организм сам начинает бороться с возбудителем, но иммунитет сохраняется на весьма малый промежуток времени. Через 2 месяца можно опять заразиться вирусом.

Важно: при прохождении лечения от инфекций нужно соблюдать диету.
Часто врачи начинают устранять следствие болезни, такие как интоксикация, температура, и другие симптомы отравления устрицами, но в случае норовируса можно всего лишь провести внутреннее вливание физраствора.
Кампилобактериоз в лечении как таковом не нуждается и проходит самостоятельно. Но в случаях, когда паразиты проникают и начинают разрушать клетки кишечника, следует принимать противомикробные препараты.
В случае Вулинификуса, перед началом лечения нужно понять тип инфекции. В варианте с раневой инфекцией рекомендуются антибиотики широкого спектра, Доксициклин. При кишечной инфекции, вызванной данным паразитом – лечение никакими веществами и препаратами можно не проводить.
При повышенной концентрации йода рекомендуется повысить норму выпиваемой воды и следить за продуктами, имеющие высокое содержание элемента.
При галофилёзе лучше всего будет обратиться к врачу и не заниматься самоизлечением.
Первая помощь в случае отравления:
- Попробовать обезвредить попавшую внутрь пищу;
- В том случае если заражённый продукт попал в человека недавно, имеет смысл сделать промывание, чтобы предотвратить всасывание в желудке;
- Спровоцировать рвоту, пить воду;
- Принять адсорбирующие препараты, такие как Полисорб или активированный уголь;
- Равноускоренно поглощать жидкость, не допуская обезвоживания;
- Заболевшего нужно изолировать от окружающих, чтобы не происходило распространения инфекции;
- Режим – постельный.

В случае заболевания ребенка или беременной женщины нужно сразу вызвать скорую помощь.
Заключение
Моллюски – вкусное и насыщенное блюдо, не стоит лишать себя такого лакомства. Чтобы не произошло отравления нужно всего лишь соблюдать гигиену и тщательно подходить к вопросу о качестве продукта и технологии приготовления. В таком случае отравления можно избежать легко и просто.
